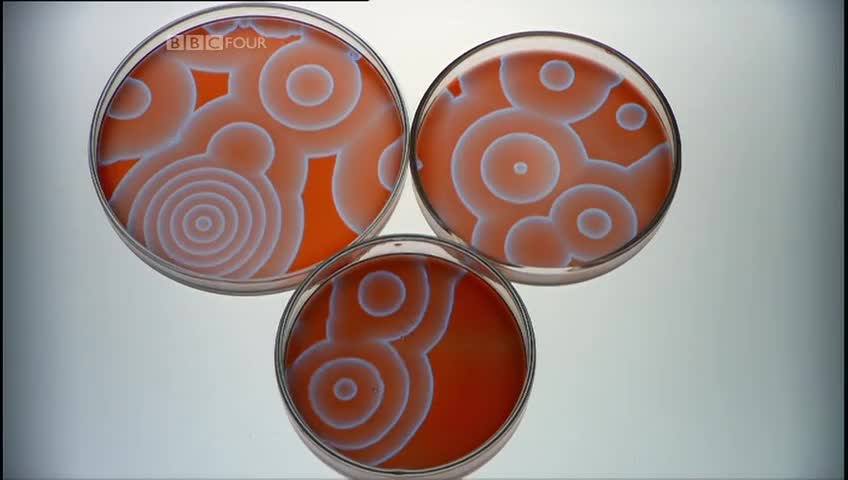

Premium Only Content
This video is only available to Rumble Premium subscribers. Subscribe to
enjoy exclusive content and ad-free viewing.
The Secret Life of Chaos
Loading comments...
-
LIVE
TheSaltyCracker
2 hours agoHail to the King ReeEEStream 10-17-25
11,732 watching -
LIVE
Flyover Conservatives
20 hours ago3 Winning Mindsets for Building Life-Changing Habits - Clay Clark; Why Employers Are Ditching DEI - Andrew Crapuchettes | FOC Show
237 watching -
LIVE
FreshandFit
3 hours ago6IX9INE Meets FreshandFit
1,249 watching -
LIVE
SynthTrax & DJ Cheezus Livestreams
22 hours agoFriday Night Synthwave 80s 90s Electronica and more DJ MIX Livestream POST DISCO / FUNK / R & B Edition
104 watching -
51:18
Degenerate Jay
10 hours agoJournalist Claims Batman Is A Fascist Like Donald Trump
862 -
1:18:27
Glenn Greenwald
6 hours agoGlenn Takes Your Questions on Major Saudi Arabia Celeb Controversies, Zohran Mamdani and the NYC Debate, Anti-ICE Protests, and More | SYSTEM UPDATE #533
79.3K13 -
1:13:26
Tundra Tactical
7 hours ago $0.99 earned🛑{LIVE NOW} Gun Nerd Plays Battlefield 6 Great Tundra Nation Get Together Day 4
3.34K1 -
LIVE
GritsGG
6 hours agoRanked Top 70! Most Wins in WORLD! 3734+!
59 watching -
LIVE
LFA TV
1 day agoLIVE & BREAKING NEWS! | FRIDAY 10/17/25
815 watching -
LIVE
Joker Effect
33 minutes agoRUMBLE COMMUNITY STREAMING NEWS - CA BANS STAKE - ARC RAIDERS - KICK LOYALS TURNING! - NEW X ALGO
465 watching